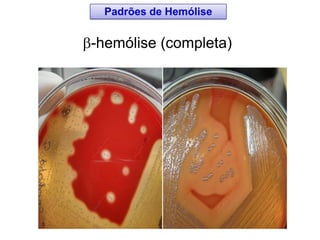
-hemólise (completa)
Padrões de Hemólise
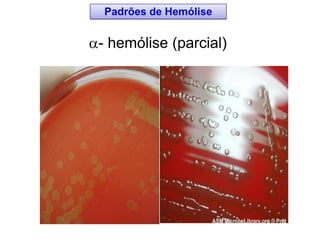
- hemólise (parcial)
Padrões de Hemólise
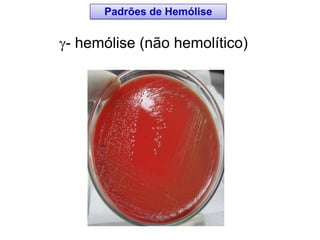
- hemólise (não hemolítico)
Padrões de Hemólise
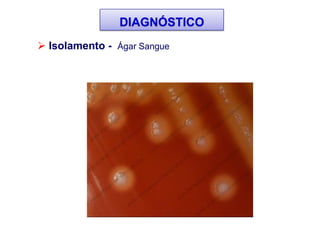
 Isolamento - Ágar Sangue
DIAGNÓSTICO
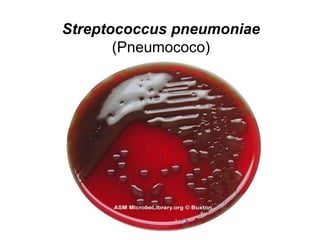
Streptococcus pneumoniae
(Pneumococo)
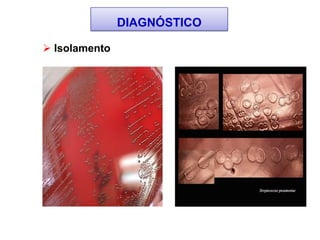
 Isolamento
DIAGNÓSTICO
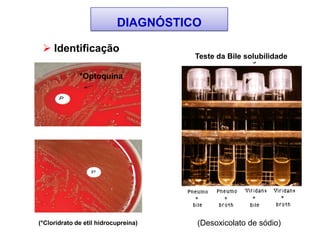
 Identificação
*Optoquina
(*Cloridrato de etil hidrocupreina)
Teste da Bile solubilidade
DIAGNÓSTICO
(Desoxicolato de sódio)

Este documento fornece informações sobre a classificação, características e importância médica do gênero Streptococcus. O documento descreve os 11 principais grupos de Streptococcus, com ênfase no grupo A (S. pyogenes), incluindo seus fatores de virulência, patogenicidade e doenças associadas como a escarlatina e febre reumática.